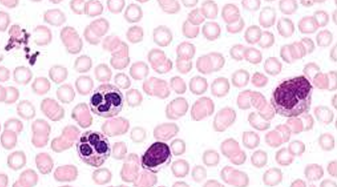
<p></p>

1/13
Looks like no tags are added yet.
Name | Mastery | Learn | Test | Matching | Spaced |
|---|
No study sessions yet.
Squamous Epithelial Tissue
· Found in: heart, blood and lymphatic vessels, body cavities, and alveoli
· Function: diffusion and protection

Cuboidal Epithelial Tissue
· Found in: kidney tubules, cover ovaries and secretory parts of certain glands
· Function: secretion of hormones, mucus, etc

Columnar Epithelial Tissue
· Found in: the ducts, digestive tract, parts of respiratory tract, and glands
· Function: Protect underlying tissue, secretion, absorption

Adipose (connective)
· Found in: almost everywhere in the body
· Function: Stores lipid (fats), Cushions, supports, and insulates the body

Areolar-Loose (connective)
· Found in: Surrounds various organs, skin and subcutaneous layer with adipose tissue
· Function: protects and cusions

Osseous (bone) tissue/ connective
· Found in: attachment points for skeletal muscles
· Function: supports and protects underlying soft tissue parts and organs

Cartilage: Hyaline/ connective
· Found in: articular bone surfaces, nose tip, bronchi, bronchial tubes
· Function: forms skeleton of embryo

Cartilage: Fibrocartilage/ connective
· Found in: between bones
· Function: found between bones wherever great strength is needed

Cartilage: Elastic cartilage/ connective
· Found in: inside auditory ear tube, external ear, epiglottis, and larynx
· Function: provides some movement and stability

Vascular/ connective
· Found in: blood vessels
· Function: Transports nutrients and oxygen to cells, takes metabolic wastes away from cells
Cardiac: Muscle tissue
· Found in: walls of the heart
· Function: allows for the contraction of the heart

Skeletal: Muscle tissue
· Found in: bones
· Function: moves bone

Smooth: Muscle tissue
· Found in: anywhere there is involuntary muscle
· Function: allows for the contraction of digestive organs

Nervous tissue-Muscle tissue
· Found in: the brain, spinal cord and nerves
· Function: Irritability- ability to respond to environmental changes/ Conductivity- ability to carry a nerve impulse
